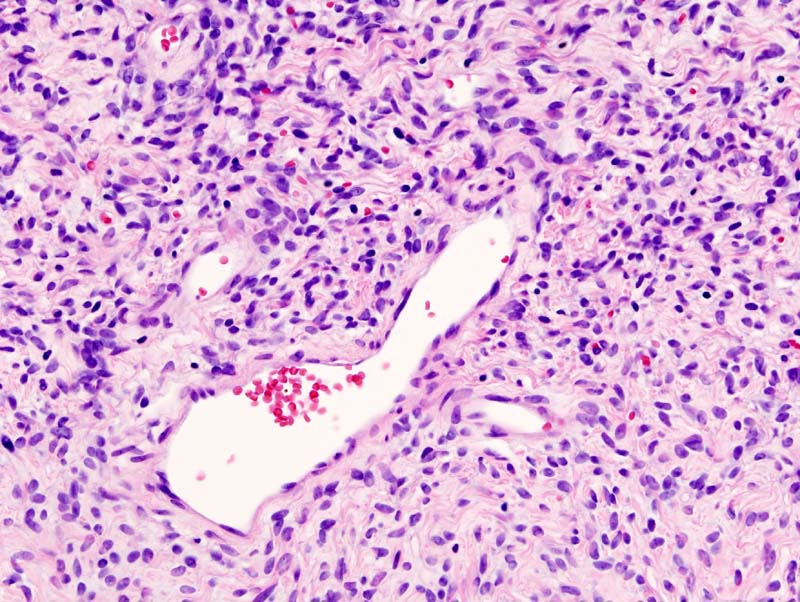

If you are searching about Solitary Fibrous Tumors(SFT) | Canada | PDF | PPT| Case Reports you've came to the right web. We have 9 Images about Solitary Fibrous Tumors(SFT) | Canada | PDF | PPT| Case Reports like Popcorn in the Lung - Journal of Thoracic Oncology, Pet ct lung cancer restaging - Answers on HealthTap and also Popcorn in the Lung - Journal of Thoracic Oncology. Here you go:
Solitary Fibrous Tumors(SFT) | Canada | PDF | PPT| Case Reports
www.omicsonline.org
www.omicsonline.org fibrous solitary tumors sft tumor pdf disease pleura malignant rare symptoms ppt articles
Small Bowel Cancer
 www.omicsonline.org
www.omicsonline.org bowel cancer tumor stomach gastric colon stool intestine stools gastrectomy blood attachment symptoms surgery abdomen lump resection
CDC - Cancer And Alcohol Infographic
alcohol cancer risk drinking prevention cdc factors infographic tobacco disease healthy cancers related diet lower health mouth raises age medicine
Small Bowel Cancer | Belgium| PDF | PPT| Case Reports | Symptoms
 www.omicsonline.org
www.omicsonline.org bowel cancer symptoms
Paraneoplastic Syndromes Of The Nervous System | Ireland| PDF | PPT
 www.omicsonline.org
www.omicsonline.org paraneoplastic syndromes nervous system symptoms syndrome ppt pdf common pathology disease cancer cell carcinoma oral treatment most squamous associated
Pet Ct Lung Cancer Restaging - Answers On HealthTap
 www.healthtap.com
www.healthtap.com lung cancer cell non pet restaging healthtap staging
Performance Status In Patients With Cancer | Oncology | JAMA Oncology
statut karnofsky oncology kps ecog definition indice jama jamanetwork formulaire
Transient Tachypnea Of Newborn Definition, Causes, Symptoms
 www.healthyatra.com
www.healthyatra.com tachypnea respiratory newborn transient virus para causes syncytial infant ingles fisioterapeutas nurses system distress técnico por ards
Popcorn In The Lung - Journal Of Thoracic Oncology
 www.jto.org
www.jto.org p1418
Tachypnea respiratory newborn transient virus para causes syncytial infant ingles fisioterapeutas nurses system distress técnico por ards. Solitary fibrous tumors(sft). Small bowel cancer
0 Comments